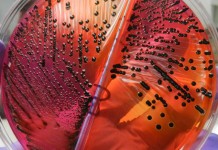
Ability to detect Salmonella vs. Salmonella-Free in poultry processing

Phosphorus: how low can we go in broiler diets?
Phosphorus (P) is essential for all forms of life. Dietary P content either in excess of, or below requirements may adversely affect broiler performance....
How to reduce antibiotics in broiler production?
There is an increased awareness recently in relation to the sensible use of antibiotics within poultry and livestock production. When looking at broiler production,...
How Xylanase can improve performance of a broiler diet
Whilst xylanase rich NSP-enzymes are used consistently in wheat based diets the question remains whether the positive response seen can be ascribed solely to...
Different light sources
The value of regulating the photoperiod of poultry and livestock to stimulate reproduction has been recognized for many years and is used regularly by...
Feather-eating hens show specific essential amino acid appetites in a double-choice model
Nutritional balance is one of the major considerations to prevent severe feather pecking in layer hens. Individual variation in digestive and metabolic efficiencies and...
Importance of hatch-time and access to feed on broiler muscle development
In commercial settings, hatching occurs over a 24-48 h window and chicks are held in the incubator until a majority have cleared the shell.
Earlier...
Pas Reform launches SmartCare™
As a future-focused business that serves the hatchery sector worldwide, Pas Reform has built its reputation as an innovator in single stage incubation technologies....
“BALTIKA”: guaranteed comfort for laying hens
TEXHA housing alternative system BALTIKA meets all the European requirements and has already been implemented by the European poultry farms
How to house happy birds by Vencomatic Group
Happy birds produce best. Aviary systems were invented to provide laying hens with maximum freedom, while using floor space efficiently. Aviaries consist of multiple...
Microbiota studies in poultry
The microbial populations that inhabit the gastrointestinal tract (GIT) of birds play an important role in the establishment and maintenance of a healthy gut....
Breeding for robustness in turkeys
Turkey breeders have invested in selection methodologies to ensure the commercial cross is capable of delivering outstanding performance with good welfare under a variety...
Outdoor broilers behavioural time budgets
The demand for free-range chicken meat is increasing. Free-range products are usually perceived as more welfare friendly by consumers and particularly fulfil the belief that the ability to perform natural behaviour leads to better welfare.
Challenges in longer laying cycle. Stabilizing egg quality
In the past 50 years, selection, initially at the breed level and then using quantitative genetics coupled with a sophisticated breeding pyramid, has resulted...
Future of Blackhead Disease in poultry
A turkey health survey of US veterinarians in turkey production ranked blackhead position #13 (#11 prior year) compared to #22 in 2006; the survey...
Rendering: an important aspect of sustainability
At the International Rendering Symposium, held in conjunction with the 2017 International Production & Processing Expo in Atlanta, Ga, it was stressed how rendering is an important aspect of sustainability. Animal agriculture in general is more sustainable with rendering processes.
The Omics revolution – Implications for animal production
What does Omics mean?
Omics is a term that refers to the recently developed high throughput technologies that include genomics, functional genomics (transcriptomics), proteomics, and...
Replacing soy in broiler diets. Effect on performance, carcass yield and cost of production
The objective of the present study was to evaluate the effect of replacing soybean meal (SBM) in broiler diets on performance, carcass quality and...
Stork Nuova CoreTech poultry evisceration
Marel Poultry is global supplier of innovative inline poultry processing equipment for broilers, turkeys and ducks, providing solutions for all process stages and all capacity levels. Now Marel Poultry developed the Stork Nuova CoreTech eviscerator to operate in emerging markets or in markets with specific or religious requirements.
Ability to detect Salmonella vs. Salmonella-Free in poultry processing
Poultry are sampled often for Salmonella during growout on the farm and throughout the processing plant. While on farm sampling is not currently a...
Fear in turkeys, implications for productivity and wellbeing
From an evolutionary standpoint, fear is an adaptive response that promotes survival by enabling animals to avoid injury and death. Because of the important impact that fear has on animal well-being, fear has formed the basis of many scientific studies and is included as part of welfare assessment programs such as the Welfare Quality Assessment Protocol for poultry.
Chick quality monitoring and diagnostics
Evaluation of chick quality in the hatchery and mortality in the field can be used to identify general problem areas: the incubator, the hatcher, or the environment after hatch.
Poultry litter quality: investigating the interrelationship between litter moisture content, pH, water activity and...
Wet litter is a recognized issue in commercial poultry production and litter quality has come under great scrutiny with the introduction of farming scheme...
Effects of early enrichment on range use in free-range laying hens
Free-range laying hen production systems are perceived to be preferable for hens’ ethological needs. However, not all hens use the range daily with some...
Selection for persistency and profitability in layers
Prof. Dr. Rudolf Preisinger, Chief Technical Officer at the EW Group, held a presentation on the selection of Lohmann’s layer lines for the traits...
Alternative systems from SPECHT
In compliance with all the current national and European legal requirements, Specht has developed three different layers housing systems which are able to meet all poultry farmers’s needs.
Visual identification of potential feather pecking
Feather pecking behaviour is common in floor-housed laying hens a behavior, which is positively associated with developing feather pecking habits.
It has been suggested that...
Taking portioning to a new era, Marel I-Cut 122 dual-lane high-speed portion cutter for...
I-Cut 122 Portion Cutter by Marel combines the highest levels of accuracy, throughput and reliability with new, innovative software.
The dual-lane I-Cut 122 has been...
Turkey breeder health, new welfare challenges and demands
The health of turkey breeders is critical to ensure the economic production of high quality fertile hatching eggs to produce poults which can be raised without antibiotics.
The trifecta for a sustainable production
To meet the needs of an additional three billion people over the next 35 years and to prevent further escalation of global poverty, agricultural production must double during this time. In meeting the increased demand for food, the interdependence between water, food and energy will become more evident and highlight resource insecurities.
Characterizing litter mite communities. Applications of DNA barcoding for management strategies
The use of DNA barcoding can facilitate rapid biodiversity assessments of fastidious taxa - litter mite communities - by delineating species using molecular operational...
Isoquinoline alkaloids lower the prevalence of salmonella Heidelberg in broiler chickens
Worldwide, tens of millions human cases are reported every year for salmonellosis. This makes it one of the most common foodborne diseases, which can...
Immediate post-hatch nutritional restriction in broilers
The effect on broiler muscle development and occurence of intramuscular fat.
Neonatal nutrition and immediate post hatch nutritional restriction represent an important facet of broiler...
Incubation temperature and how it influences chick hatch time and bone ash
With commercial broilers spending up to 30% of their lifespan in the egg, incubation temperature has been linked to some leg weakness issues.
The recommended...
Quick molt diets and programs
Induced molting is a process conducted by many commercial egg producers to extend the productive life of the laying hen. The main objective of...
Automated assessment of health and welfare in commercial broiler chicken flocks using optical flow
Assessing the health and welfare of growing broiler chickens is mainly done post mortem, using measures taken at the slaughter plant (% birds with...
Integrated Microfluidic Device for rapid Avian Influenza virus capture
Rapid detection of avian influenza virus (AIV) is highly desirable during outbreaks or routine AIV surveillance.
In this project, the preliminary results in developing a...
Influence of feed form and particle size on the performance and nutrient utilisation of...
The present experiment was designed to examine the influence of feed form and particle size in maize-based diets on the performance and nutrient utilisation...
H&N celebrated 70 years of excellent performances worldwide
To celebrate its 70-year success story and launch its new company logo, H&N gathered its distributors and customers in a two-day event in Bangkok. All these customers shared the same vision and experience: H&N layers are persistent and highly productive. Moreover they produce high quality eggs, meeting the demands of modern consumers.
Probiotics as an alternative to antibiotics for treating lameness in broilers
The pathogenesis leading to a form of lameness known as bacterial chondronecrosis with osteomyelitis (BCO) appears to be initiated by mechanical microfracturing of susceptible...
Global phosphorus scarcity
Phosphorus scarcity is a serious threat to food security. Recent studies indicate that phosphorus demand could outstrip finite supplies of high quality phosphatesometime between 2025-2084 if no fundamental changes are made to the current trajectory.
Bacterin usage
A good vaccination program, along with proper flock management and biosecurity, plays a key role in the health and productivity of broiler breeders. The...
A practical approach to broiler breeder management in the absence of beak treatment –...
In the absence of beak treatment management strategies, which ensure appropriate bird development and growth and the provision of adequate environment and stimuli, which...